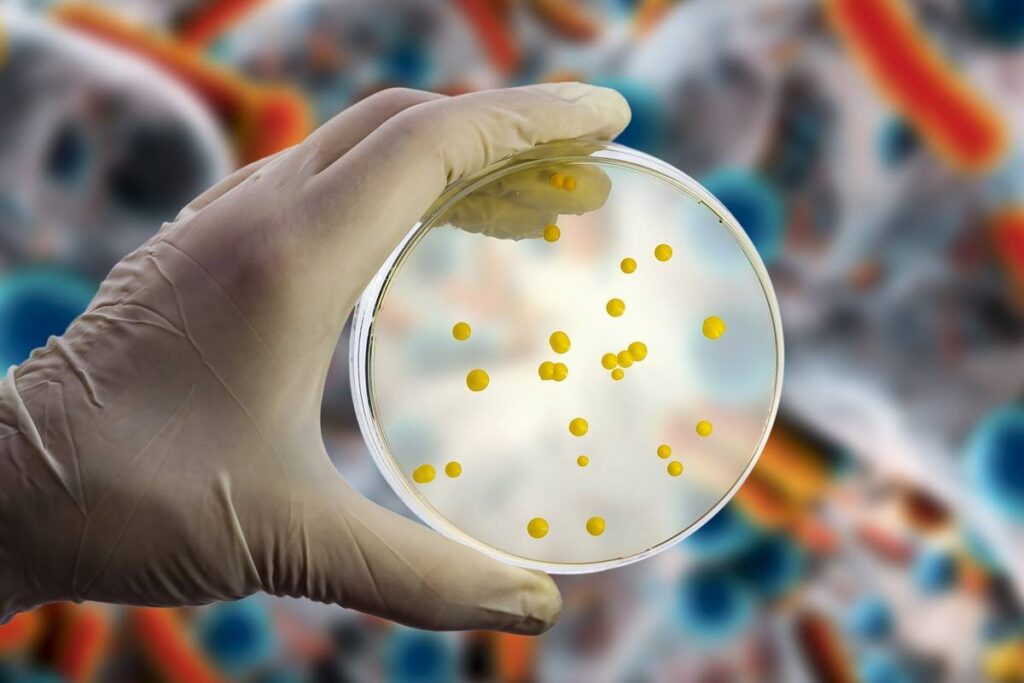

Pesquisadores suíços descobriram 35 novas espécies de bactérias nunca descritas antes em amostras de pacientes hospitalizados no país. A descoberta foi divulgada na sexta-feira (5/1) pela Universidade da Basileia, na Suíça.
As bactérias são organismos unicelulares que podem causar diferentes doenças em seres humanos, algumas delas extremamente graves. Conhecer as espécies por trás das infecções bacterianas é fundamental para que o paciente receba o tratamento correto e tenha maiores chances de cura.
Nos últimos dez anos, a equipe do microbiologista Daniel Goldenberger analisou 61 patógenos bacterianos desconhecidos encontrados em amostras de sangue ou tecidos de pacientes hospitalizados com uma ampla gama de condições médicas.
Das 61 bactérias coletadas, 35 eram desconhecidas até então. Entre essas, sete eram clinicamente relevantes, ou seja, podem causar infecções bacterianas em humanos.
As bactérias podem causar doenças graves quando não são corretamente tratadas
A maioria das espécies identificadas pertence aos gêneros Corynebacterium e Schaalia, ambos bacilos gram-positivos que podem causar infecções quando entram na corrente sanguínea. “Muitas espécies desses dois gêneros são encontradas no microbioma natural da pele humana e na mucosa. É por isso que são frequentemente subestimados e as pesquisas sobre eles são escassas”, explica Goldenberger.
As outras 26 bactérias foram classificadas como “difíceis de identificar”. Isso quer dizer que as sequências genômicas só tinham sido adicionadas recentemente às bases de dados ou uma descrição taxonômica correta dos agentes patogénicos só foi criada há pouco tempo.
Siga a editoria de Saúde no Instagram e fique por dentro de tudo sobre o assunto!